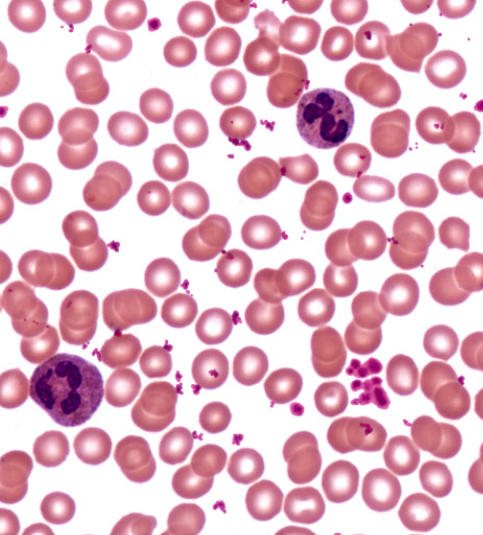
knowt flashcard image

1/72
Looks like no tags are added yet.
Name | Mastery | Learn | Test | Matching | Spaced | Call with Kai |
|---|
No analytics yet
Send a link to your students to track their progress
Taste bud

Taste pore

Rod

Cone

Optic disk

Optic nerve

Ciliary body

Anterior chamber

Posterior chamber

Retina

Suspensory ligaments (of lens)

inferior oblique muscle

Superior oblique muscle

Vallate papilla

Olfactory mucosa

Olfactory tract

Zona glomerulosa

Zona fasciculata

Zona reticularis

Anterior pituitary

Posterior pituitary

Infundibulum

Thyroid follicle

Parafollicular cell

Pancreatic alpha cell

Pancreatic beta cell

adrenal cortex

Suprarenal (adrenal) medulla

Isthmus of thyroid gland

thyroid gland

Body of pancreas

head of pancreas

Neck of pancreas

Tail of pancreas

Ovary

Erythrocyte

platelet
Arteriole

Venule

Coronary sulcus

Posterior interventricular sulcus

Ascending aorta

Pulmonary trunk

Superior vena cava

inferior vena cava

Coronary sinus

Great cardiac vein

Small cardiac vein

aortic arch

Thoracic aorta

Abdominal aorta

aortic (semilunar) valve

Pulmonary (semilunar) valve

Left atrioventricular (bicuspid) valve

Right atrioventricular (tricuspid) valve

Interatrial septum

trabeculae carneae

Papillary muscle

Pectinate muscle

Fossa ovalis

Fibrous pericardium

Parietal (layer of serous) pericardium

Visceral pericardium

Hepatic portal vein

Brachiocephalic trunk

Azygos vein

Common carotid artery

External carotid artery

Internal carotid artery

Vertebral artery

Basilar artery

internal jugular vein

External jugular vein
